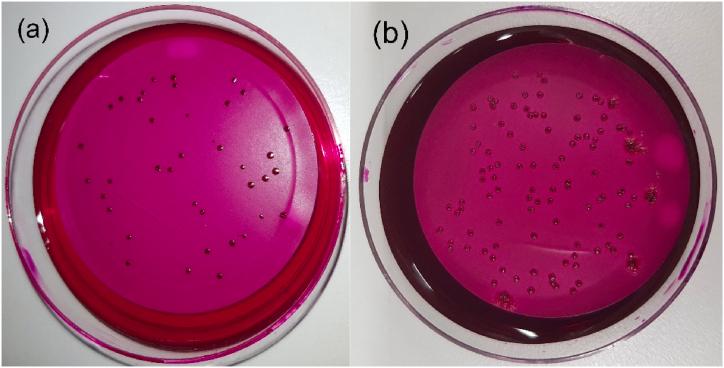
https://cdn.ncbi.nlm.nih.gov/pmc/blobs/d555/10643266/c027ede6357b/gr1.jpg

瓶装矿泉水中[具体物质]和[具体物质]的行为。 (你提供的原文中“and”前后缺少具体内容)
The behaviour of and in bottled mineral water.
作者信息
Schalli Michael, Platzer Sabine, Haas Doris, Reinthaler Franz F
机构信息
Department for Water-Hygiene and Micro-Ecology, D&R Institute of Hygiene, Microbiology and Environmental Medicine, Medical University of Graz, 8010, Graz, Austria.
Applied Hygiene and Aerobiology, D&R Institute of Hygiene, Microbiology and Environmental Medicine, Medical University of Graz, 8010, Graz, Austria.
出版信息
Heliyon. 2023 Oct 30;9(11):e21634. doi: 10.1016/j.heliyon.2023.e21634. eCollection 2023 Nov.
Microbial contamination of bottled water during the filling and capping procedure is a problem which should be avoided. The examination of the influence of carbon dioxide (CO) on bacterial growth of () and () in bottled mineral water was the aim of this study. Commercially available glass bottles with plastic screw caps filled with natural mineral water (without additional CO "still" (StMW) and with CO "sparkling" (SpMW) were obtained from a manufacturer in the province of Styria, Austria. The artificial contamination was performed in the lab by opening the bottle with subsequent addition of a bacterial solution with a defined number of bacteria. For each bacterial strain, 12 bottles were prepared. Samples (100 mL) were taken after a specific number of days, filtrated and placed on Endo Agar for cultivation. After incubation for 24 h bacterial colonies were counted. In this study CO addition to bottled water reduced colony forming units of the two investigated bacterial strains over time.
瓶装水在灌装和封盖过程中的微生物污染是一个应避免的问题。本研究的目的是考察二氧化碳(CO)对瓶装矿泉水中(此处括号内容缺失,无法准确翻译)和(此处括号内容缺失,无法准确翻译)细菌生长的影响。从奥地利施蒂利亚州的一家制造商处获得了市售的带有塑料螺旋盖的玻璃瓶,瓶中装有天然矿泉水(无额外CO₂的“静止”水(StMW)和含CO₂的“气泡”水(SpMW))。在实验室中通过打开瓶子并随后添加含有特定数量细菌的细菌溶液进行人工污染。对于每种细菌菌株,制备了12瓶。在特定天数后取样品(100 mL),过滤后置于伊红美蓝琼脂上进行培养。培养24小时后计数细菌菌落。在本研究中,向瓶装水中添加CO₂会随着时间的推移减少两种被研究细菌菌株的菌落形成单位。